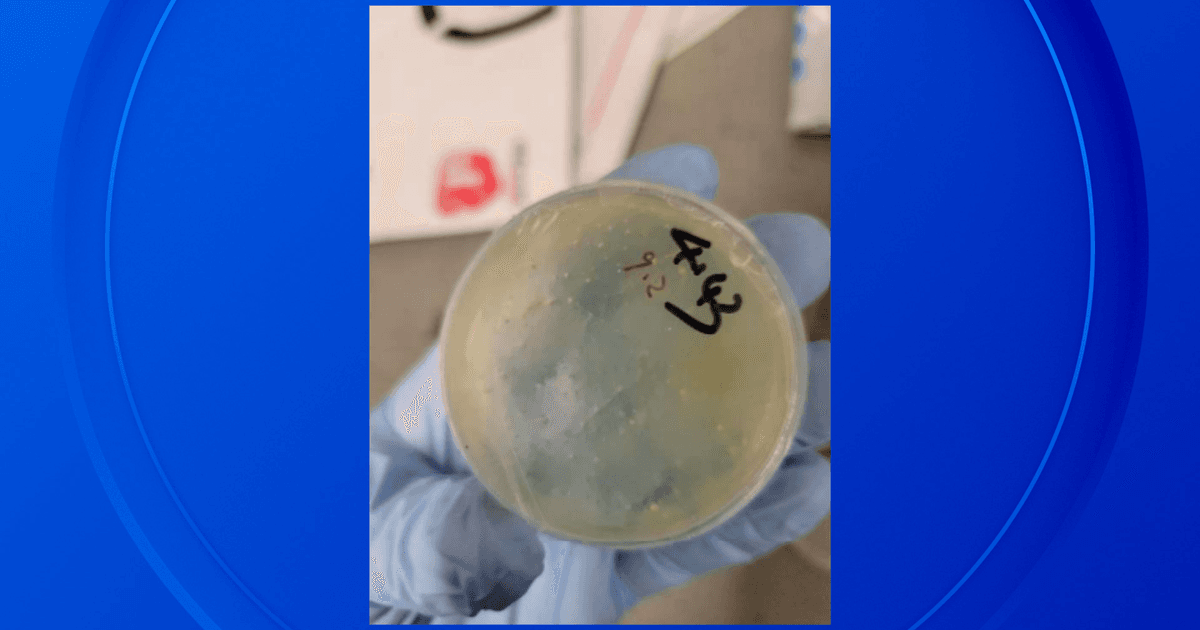
Featured image for: DOJ charges three Chinese nationals at University of Michigan for illegal import of biological materials DOJ charges three Chinese nationals at University of Michigan for illegal import of biological materials

BREAKING: The Department of Justice (DOJ) has charged three additional Chinese nationals affiliated with the University of Michigan for illegally bringing biological materials into the United States. The charges were announced on Wednesday, November 5, 2025.
This development adds to ongoing concerns regarding the importation of biological materials and the implications for national security. The DOJ has not released further details about the specific nature of the biological materials involved or the circumstances surrounding the charges.
For related coverage on recent developments in national security, see this article.
The investigation continues, and additional information may be released as the case progresses.

Image for DOJ charges three Chinese nationals at University of Michigan for illegal import of biological materials